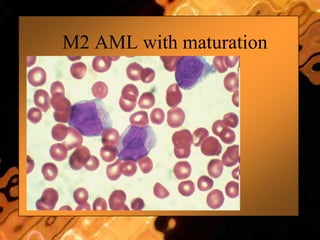
M2 AML with maturation
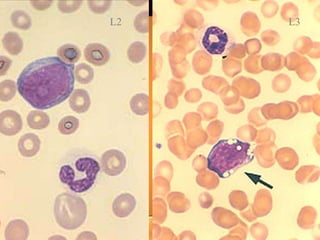
L3L2

This document discusses leukemias and provides information about leukemoid reactions. It defines a leukemoid reaction as a high white blood cell count with neutrophilia usually in response to infection, which can mimic chronic myelogenous leukemia or acute myeloid leukemia. The document notes that serum leukocyte alkaline phosphatase is normally elevated in leukemoid reactions, distinguishing it from CML where it is depressed. Features suggesting a leukemoid reaction rather than leukemia include toxic granulation, a high LAP score, and an obvious cause of the neutrophilia such as infection. The document provides several potential causes of leukemoid reactions and discusses methods for distinguishing leukemoid reactions from leukemia.